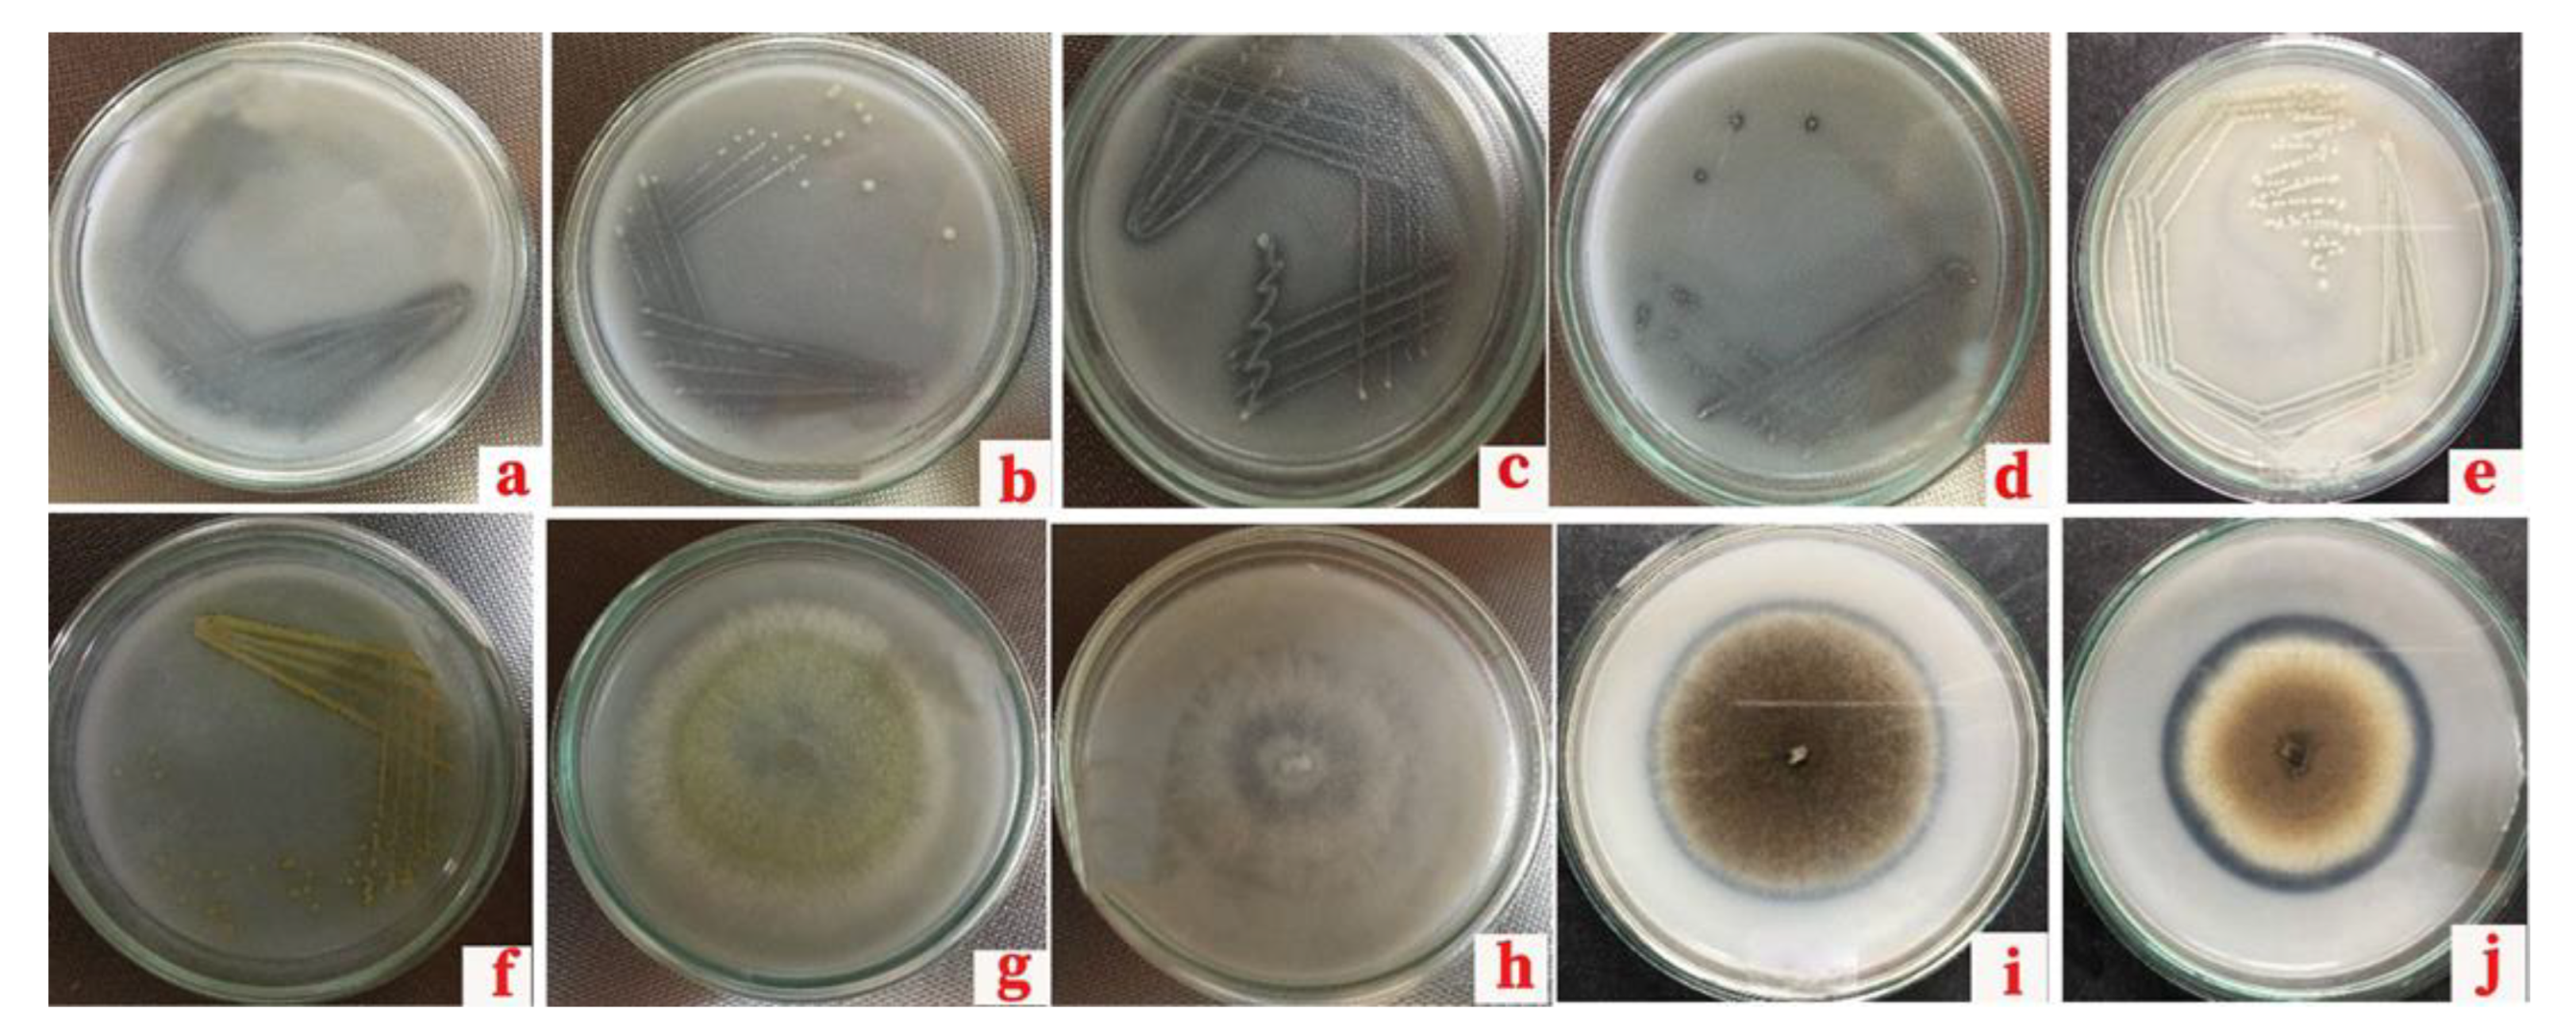
Life 13 00782 g001

Isolation of Phosphate-Solubilizing Microorganisms and the Formulation of Biofertilizer for Sustainable Processing of Phosphate Rock
Abstract
1. Introduction
2. Materials and Methods
2.1. Study Site
2.2. Sample Collection
2.3. Isolation and Identification of Phosphate-Solubilizing Microorganisms
2.4. Evaluation of the Phosphate-Solubilizing Capability of PSMs
2.4.1. Quantification of Phosphate Solubilization
2.4.2. Determination of Available Phosphorus
Preparation of Extracting Solution
Preparation of the Vanadate-Molybdate Reagent
Preparation of Standard Phosphate Solutions
Preparation of Unknown Soil, ERP, and TCP Solutions
Determination of P Concentration
2.5. Preparation of the Biofertilizer
2.6. Pot Trial for Determination of the Effect of the Biofertilizer
2.6.1. Design of the Treatments
2.6.2. Application of Biofertilizer
2.6.3. Determining the Effect of the Biofertilizer
2.7. Statistical Analysis
3. Results
3.1. Measured Parameters of the Collected Samples
3.2. Isolation and Identification of PSMs
3.3. Evaluation of the Phosphate-Solubilizing Capability of Phosphate-Solubilizing Microorganisms
3.4. Quantification of Phosphate Solubilization
3.4.1. pH Values of the Microbial-Enriched Culture Broths
3.4.2. Improvement of Available Phosphorus in Microbial-Enriched Culture Broths
3.4.3. Selected Microorganisms for the Biofertilizer
3.4.4. Correlation between Available P Concentration and pH of the ERP Broth
3.5. Determining the Effect of the Biofertilizer
3.5.1. Electrical Conductivity
3.5.2. pH
3.5.3. Available P Concentration
3.6. Effect of Biofertilizer on Plant Growth
3.6.1. Correlation between Available P and pH in the Pot Trial
3.6.2. Correlation between Available P and Plant Height
3.6.3. Correlation between Total Bacterial Count and Total PSM Count in the Pot Trial
4. Discussion
5. Conclusions
Author Contributions
Funding
Institutional Review Board Statement
Informed Consent Statement
Data Availability Statement
Acknowledgments
Conflicts of Interest
References
- Kalayu, G. Phosphate solubilizing microorganisms: Promising approach as biofertilizers. Int. J. Agron. 2019, 7, 4917256. [Google Scholar] [CrossRef]
- Alori, E.T.; Glick, B.R.; Babalola, O.O. Microbial phosphorus solubilization and its potential for use in sustainable agriculture. Front. Microbiol. 2017, 8, 00971. [Google Scholar] [CrossRef] [PubMed]
- Panhwar, Q.A.; Radziah, O.; Saharah, A.; Sariah, M.; Razi, I. Role of phosphate solubilizing bacteria on rock phosphate solubility and growth of aerobic rice. J. Environ. Biol. 2011, 32, 607–612. [Google Scholar]
- Dahanayake, K.; Subasinghe, S.M.N.D. Mineralogical, chemical and solubility variations in the Eppawala phosphate deposit of Sri Lanka--A case for selective mining for fertilizers. Fertil. Res. 1991, 28, 233–238. [Google Scholar] [CrossRef]
- Chen, Y.P.; Rekha, P.D.; Arun, A.B.; Shen, F.T.; Lai, W.A.; Young, C.C. Phosphate solubilizing bacteria from subtropical soil and their tricalcium phosphate solubilizing abilities. Appl. Soil Ecol. 2006, 34, 33–41. [Google Scholar] [CrossRef]
- Achal, V.; Savant, V.V.; Reddy, M.S. Phosphate solubilization by a wild type strain and UV-induced mutants of Aspergillus tubingensis. Soil Biol. Biochem. 2007, 39, 695–699. [Google Scholar] [CrossRef]
- Zhu, H.; Sun, L.; Zhang, Y.; Zhang, X.; Qiao, J. Bioresource technology conversion of spent mushroom substrate to biofertilizer using a stress-tolerant phosphate-solubilizing Pichia farinose FL7. Bioresour. Technol. 2012, 111, 410–416. [Google Scholar] [CrossRef]
- Babalola, O.O.; Glick, B.R. Indigenous african agriculture and plant associated microbes: Current practice and future transgenic prospects. Sci. Res. Essays 2012, 7, 2431–2439. [Google Scholar]
- Wani, P.; Khan, M.; Zaidi, A. Co-inoculation of nitrogen-fixing and phosphate-solubilizing bacteria to promote growth, yield and nutrient uptake in chickpea. Acta Biol. Hung. 2007, 55, 315–323. [Google Scholar] [CrossRef]
- Rodriguez, H.; Fraga, V. Phosphate solubilizing bacteria and their role in plant growth promotion. Biotechnol. Adv. 1999, 17, 319–339. [Google Scholar] [CrossRef]
- Tallapragada, P.; Gudimi, M. Phosphate solubility and biocontrol activity of Trichoderma harzianum. Turk. J. Biol. 2011, 35, 8. [Google Scholar] [CrossRef]
- Van Straaten, P. International Centre for Research in Agroforestry. 2002. Available online: http://apps.worldagroforestry.org/Units/Library/Books/PDFs/11_Rocks_for_crops.pdf (accessed on 20 March 2022).
- Shrivastava, M.; Kale, S.P.; Souza, S.F.D. Rock phosphate enriched post-methanation bio-sludge from kitchen waste based biogas plant as P source for mungbean and its effect on rhizosphere phosphatase activity. Eur. J. Soil Biol. 2011, 47, 205–212. [Google Scholar] [CrossRef]
- Khan, M.; Ahmad, S.; Sharif, M.; Billah, M.; Aslam, M. Formulation of single super phosphate fertilizer from rock phosphate of Hazara, Pakistan. Soil Sci. Soc. Pak. 2012, 31, 96–99. [Google Scholar]
- Kang, S.C.; Ha, C.G.; Maheshvari, D.K. Solubilization of insoluble inorganic phosphates by a soil-inhabiting fungus Fomitopsis sp. PS 102. Curr. Sci. 2021, 82, 439–442. [Google Scholar]
- Afzal, A. Rhizobium and phosphate solubilizing bacteria improve the yield and phosphorus uptake in wheat (Triticum aestivum). Int. J. Agric. Biol. 2014, 10, 85–88. [Google Scholar]
- Tarafdar, J.C.; Gharu, A. Mobilization of organic and poorly soluble phosphates by Chaetomium globosum. Appl. Soil Ecol. 2006, 32, 273–283. [Google Scholar] [CrossRef]
- Ogbo, F.C. Conversion of cassava wastes for biofertilizer production using phosphate solubilizing fungi. Bioresour. Technol. 2010, 101, 4120–4124. [Google Scholar] [CrossRef]
- Biswas, D.R.; Narayanasamy, G. Rock phosphate enriched compost: An approach to improve low-grade Indian rock phosphate. Bioresour. Technol. 2006, 97, 2243–2251. [Google Scholar] [CrossRef]
- Mcgill, W.B.; Cole, C.V. Comparative aspects of cycling of organic C, N, S and P through soil organic matter. Geoderma 1981, 26, 267–286. [Google Scholar] [CrossRef]
- Department of Meteorology. Weather Forecast. 2021. Available online: https://www.weather-atlas.com/en/Srilanka (accessed on 22 March 2022).
- Manzoor, M.; Abbasi, M.K.; Sultan, T. Isolation of phosphate solubilizing bacteria from maize rhizosphere and their potential for rock phosphate solubilization—Mineralization and plant growth promotion. Geomicrobiol. J. 2017, 34, 81–95. [Google Scholar] [CrossRef]
- Sagervanshi, A.; Kumari, P.; Nagee, A. Isolation and characterization of phosphate solublizing bacteria from anand agriculture soil. Int. J. Life Sci. Pharma. Res. 2012, 2, 256–266. [Google Scholar]
- Xiao, C.; Chi, R.; He, H. Isolation of phosphate-solubilizing fungi from phosphate mines and their effect on wheat seedling growth. Appl. Biochem. Biotechnol. 2009, 159, 330–342. [Google Scholar] [CrossRef] [PubMed]
- Sharma, S.; Kumar, V.B.; Tripathi, R. Isolation of phosphate solubilizing microorganism (PSMs) from soil. J. Microbiol. Biotechnol. Res. 2017, 1, 90–95. [Google Scholar]
- Yu, X.; Liu, X.; Zhu, T.; Liu, G.; Mao, C. Isolation and characterization of phosphate-solubilizing bacteria from walnut and their effect on growth and phosphorus mobilization. Biol. Fertil. Soils 2011, 47, 437–446. [Google Scholar] [CrossRef]
- Reza, M.; Bahman, S.; Ralf, K. Isolation and identification of temperature tolerant phosphate solubilizing bacteria as a potential microbial fertilizer. World J. Microbiol. Biotechnol. 2019, 35, 126. [Google Scholar]
- Rajani, A. Forms of Phosphorus. 2019. Available online: https://www.researchgate.net/publication/335209942_Forms_of_phosphorus (accessed on 25 February 2022).
- Olsen, S.R.; Sommers, L.E. Methods of Soil Analysis, Chemical and Microbiological Properties; American Society of Agronomy: Madison, WI, USA; Soil Science Society of America: Madison, WI, USA, 1982. [Google Scholar]
- Bray, R.H.; Kurtz, L.T. Determination of total, organic, and available forms of phosphorus in soils. Soil Sci. 1945, 59, 39–46. [Google Scholar] [CrossRef]
- FAO. Standard Operating Procedure for Soil Available Phosphorus—Olsen Method; Food and Agriculture Organization of United States: Rome, Italy, 2021. [Google Scholar]
- Lass-Florl, C.; Cuenca-Estrella, M.; Denning, D.W.; Rodriguez-Tudela, J.L. Antifungal susceptibility testing in Aspergillus spp. according to EUCAST methodology. Med. Mycol. J. 2006, 44, 319–325. [Google Scholar] [CrossRef]
- Yapa, P.N.; Pathirana, B.K. Evaluation of different carrier substances for the development of an effective evaluation of effective pelleted biofertilizer for rice (Oryza sativa L.) using co-inoculated bacteria and arbuscular mycorrhizal fungi. Asian J. Biotechnol. Bioresour. Technol. 2020, 6, 1–10. [Google Scholar]
- Shravani, K.; Triveni, S.; Latha, P.C.; Damodara Chari, K. Evaluation of shelf life and quality of carrier and liquid based biofertilizers. Int. J. Microbiol. Res. 2019, 11, 1598–1601. [Google Scholar]
- Department of Agriculture. 2015. Available online: http://web2.doa.gov.lk/FCRDI/index.php/en/crop/34-chilli (accessed on 22 March 2022).
- Umayangani, C.; Malaviarachchi, W.; Hettiarachchi, R.; Yapa, P.N. Different sources of phosphorus fertilizers and soil amendments affected the phosphorus and cadmium content in soil, roots and seeds of maize (Zea mays L.). Turk. J. Agric. Food Sci. Technol. 2021, 9, 640–645. [Google Scholar] [CrossRef]
- Chen, Q.; Liu, S. Identification and characterization of the phosphate-solubilizing bacterium Pantoea sp. S32 in reclamation soil in Shanxi, China. Front. Microbiol. 2019, 10, 2171. [Google Scholar] [CrossRef] [PubMed]
- Chuang, C.C.; Kuo, Y.L.; Chao, C.C.; Chao, W.L. Solubilization of inorganic phosphates and plant growth promotion by Aspergillus niger. Biol. Fertil. Soils 2007, 43, 575–584. [Google Scholar] [CrossRef]
- Onyia, C.E.; Anyawu, C.U.; Ikegbunam, M.N. Ability of fungi, isolated from nsukka peppers and garden-eggplant rhizospheres, to solubilize phosphate and tolerate cadmium. Adv. Microbiol. 2015, 5, 500–506. [Google Scholar] [CrossRef]
- Kpomblekou-a, K.; Tabatabai, M.A. Effect of organic acids on release of phosphorus from phosphate rocks. Soil Sci. 1994, 158, 442–453. [Google Scholar] [CrossRef]
- Reyes, I.; Bernier, L.; Simard, R.; Antoun, H. Effect of nitrogen source on the solubilization of different inorganic phosphates by an isolate of Penicillium rugulosum and two UV-induced mutants. FEMS Microbiol. Ecol. 1999, 28, 281–290. [Google Scholar] [CrossRef]
- Illmer, P.; Schinner, F. Solubilization of inorganic calcium phosphates-solubilization mechanisms. Soil Biol. Biochem. 1995, 27, 257–263. [Google Scholar] [CrossRef]
- Hwangbo, H. 2-Ketogluconic acid production and phosphate solubilization by Enterobacter intermedium. Curr. Microbiol. 2003, 47, 87–92. [Google Scholar]
- Mylavarapu, R.; Bergeron, J.; Wilkinson, N. Soil pH and Electrical Conductivity: A County Extension Soil Laboratory Manual. UF/IFAS Electronic Data Information System. 2020. Available online: https://edis.ifas.ufl.edu/publication/SS118 (accessed on 1 April 2022).
- Mittal, V.; Singh, O.; Nayyar, H.; Kaur, J.; Tewari, R. Stimulatory effect of phosphate-solubilizing fungal strains (Aspergillus awamori and Penicillium citrinum) on the yield of chickpea (Cicer arietinum L. c.v. GPF2). Soil Biol. Biochem. 2008, 40, 718–727. [Google Scholar] [CrossRef]
- El-Tarabily, K.A.; Nassar, A.H.; Sivasithamparam, K. Promotion of growth of bean (Phaseolus vulgaris L.) in a calcareous soil by a phosphate-solubilizing, rhizosphere-competent isolate of Micromonospora endolithica. Appl. Soil Ecol. 2008, 39, 161–171. [Google Scholar] [CrossRef]
- Amri, M.; Mateus, D.; Gatrouni, M.; Rjeibi, M.R.; Asses, N.; Abbes, C. Co-Inoculation with Phosphate-Solubilizing Microorganisms of Rock Phosphate and Phosphogypsum and Their Effect on Growth Promotion and Nutrient Uptake by Ryegrass. Appl. Biosci. 2022, 1, 179–197. [Google Scholar] [CrossRef]
- Miethling, R.; Wieland, G.; Backhaus, H.; Tebbe, C.C. Variation of microbial rhizosphere communities in response to crop species, soil origin and inoculation with Sinorhizobium meliloti L33. Microb. Ecol. 2000, 41, 43–56. [Google Scholar] [CrossRef] [PubMed]
- Williams-Linera, G.; Ewel, J.J. Effect of autoclave sterilization of a tropical an dept on seed germination and seedling growth. Plant Soil 1984, 82, 263–268. [Google Scholar] [CrossRef]

| Treatment | ERP (g) | TCP (g) | Biofertilizer (mL) | Nitrogen (g) | Potassium (g) |
|---|---|---|---|---|---|
| T1-Control | – | – | – | 0.1222 | 0.0474 |
| T2-ERP | 0.1147 | – | – | 0.1222 | 0.0474 |
| T3-TCP | – | 0.1147 | – | 0.1222 | 0.0474 |
| T4-ERP + Biofertilizer | 0.1147 | – | 20.000 | 0.1222 | 0.0474 |
| T5-TCP + Biofertilizer | – | 0.1147 | 20.000 | 0.1222 | 0.0474 |
| T6-Biofertilizer | – | – | 20.000 | 0.1222 | 0.0474 |
| Soil Sample | pH Value | Electrical Conductivity (µs) | Available Phosphorus (mg/L) | Total Bacterial Population (log CFU/g) | Total Fungal Population (log CFU/g) | Total Phosphate-Solubilizing Population (log CFU/g) |
|---|---|---|---|---|---|---|
| Eppawala | 6.90 ± 0.01 | 47.68 ± 0.02 | 25.00 ± 0.05 | 10.95 ± 1.00 | 5.47 ± 0.50 | 6.23 ± 0.50 |
| Kandy | 5.18 ± 0.01 | 214.80 ± 0.15 | 39.30 ± 0.15 | 10.07 ± 1.00 | 6.60 ± 1.00 | 6.00 ± 0.50 |
| Kegalle (Tea) | 5.85 ± 0.02 | 49.49 ± 0.01 | 65.00 ± 0.10 | 10.90 ± 0.50 | 5.90 ± 0.50 | 6.14 ± 1.00 |
| Kegalle (Rubber) | 5.38 ± 0.01 | 37.77 ± 0.12 | 58.00 ± 0.05 | 10.84 ± 0.50 | 5.77 ± 1.00 | 6.23 ± 1.50 |
| Mihintale | 7.14 ± 0.02 | 540.80 ± 0.10 | 43.30 ± 0.15 | 10.14 ± 1.00 | 7.00 ± 3.00 | 6.00 ± 1.00 |
| Eppawala Rock Phosphate | 6.95 ± 0.02 | 72.73 ± 0.01 | 252.57 ± 0.31 | 10.69 ± 1.00 | 7.30 ±0.50 | 7.30 ± 2.50 |
| Isolate | Colony Diameter (mm) | Halozone Diameter (mm) | Color | Shape | Margin | Opacity | Elevation | Surface |
|---|---|---|---|---|---|---|---|---|
| B1 | 0.50 ± 0.01 | 2.50 ± 0.08 | White | Round | Entire | Opaque | Flat | Smooth |
| B2 | 5.00 ± 0.06 | 6.50 ± 0.06 | Cream | Round | Undulate | Opaque | Raised | Smooth |
| B3 | 0.30 ± 001 | 2.00 ± 0.06 | White | Round | Entire | Opaque | Flat | Smooth |
| B4 | 0.50 ± 0.03 | 2.10 ± 0.03 | White | Round | Entire | Opaque | Flat | Smooth |
| B5 | 3.00 ± 0.06 | 4.70 ± 0.06 | White | Round | Entire | Opaque | Raised | Smooth |
| B6 | 2.00 ± 0.03 | 3.20 ± 0.06 | White | Round | Entire | Opaque | Flat | Smooth |
| B7 | 1.50 ± 0.03 | 2.90 ± 0.06 | White | Round | Undulate | Opaque | Raised | Smooth |
| B8 | 1.20 ± 0.04 | 2.90 ± 0.03 | White | Round | Entire | Opaque | Flat | Smooth |
| B9 | 4.00 ± 0.06 | 5.80 ± 0.06 | Cream | Round | Entire | Opaque | Flat | Smooth |
| B10 | 3.00 ± 0.03 | 4.20 ± 0.06 | White | Round | Entire | Opaque | Flat | Smooth |
| B11 | 2.00 ± 0.06 | 3.60 ± 0.06 | Cream | Round | Entire | Opaque | Raised | Smooth |
| B12 | 1.50 ± 0.03 | 2.70 ± 0.03 | White | Round | Entire | Opaque | Flat | Smooth |
| B13 | 1.20 ± 0.03 | 3.10 ± 0.03 | Yellow | Irregular | Lobate | Opaque | Raised | Rugose |
| Isolate | Colony Color (Front Site) | Colony Color (Back Site) | Colony Diameter (mm) | Halozone Diameter (mm) |
|---|---|---|---|---|
| F1 | Initially white, became dark green with white periphery | White | 2.20 ± 0.03 | 3.50 ± 0.06 |
| F2 | White | White | 7.00 ± 0.06 | 8.30 ± 0.06 |
| F3 | White | White | 4.10 ± 0.06 | 5.80 ± 0.08 |
| F4 | White | White | 8.00 ± 0.08 | 9.20 ± 0.06 |
| F5 | Initially white, turned black rapidly | White to pale yellow | 9.00 ± 0.03 | 11.80 ± 0.03 |
| F6 | White | White | 3.80 ± 0.06 | 4.90 ± 0.08 |
| F7 | Initially white, turned black rapidly | White to pale yellow | 6.90 ± 0.06 | 8.10 ± 0.03 |
| F8 | Initially white, turned black rapidly | Pale yellow | 7.60 ± 0.06 | 9.50 ± 0.03 |
| F9 | White | White | 6.50 ± 0.03 | 7.20 ± 0.06 |
| F10 | Initially white, turned black rapidly | Pale yellow | 7.00 ± 0.03 | 9.60 ± 0.06 |
| F11 | Green | White | 5.20 ± 0.06 | 5.80 ± 0.03 |
| Isolate | Gram Stain, Cell Shape | Endospore Stain | Catalase Test | Starch Hydrolysis Test | Casein Hydrolysis Test | Gelatin Hydrolysis Test | Oxidase Test |
|---|---|---|---|---|---|---|---|
| B1 | G +, Coccus | − | − | − | − | − | − |
| B2 | G +, Rod | − | + | + | − | − | − |
| B3 | G +, Coccus | − | − | – | − | − | − |
| B4 | G +, Coccus | − | − | – | − | − | − |
| B5 | G −, Rod | − | + | – | − | − | + |
| B6 | G −, Rod | − | + | + | − | − | − |
| B7 | G +, Rod | − | + | + | − | − | + |
| B8 | G −, Rod | − | + | – | − | − | − |
| B9 | G +, Rod | + | + | + | – | − | − |
| B10 | G −, Rod | − | + | – | – | + | − |
| B11 | G −, Rod | + | + | – | + | – | + |
| B12 | G +, Rod | + | + | – | – | – | + |
| Microbial Culture | Phosphate Solubilization Index |
|---|---|
| B1 | 6.00 ± 0.20 |
| B2 | 2.30 ± 0.12 |
| B3 | 7.67 ± 0.14 |
| B4 | 5.20 ± 0.08 |
| B5 | 2.57 ± 0.03 |
| B6 | 2.60 ± 0.16 |
| B7 | 2.93 ± 0.09 |
| B8 | 3.42 ± 0.04 |
| B9 | 2.45 ± 0.17 |
| B10 | 2.40 ± 0.08 |
| B11 | 2.80 ± 0.14 |
| B12 | 2.80 ± 0.09 |
| B13 | 3.58 ± 0.12 |
| F1 | 2.59 ± 0.03 |
| F2 | 2.18 ± 0.06 |
| F3 | 2.41 ± 0.04 |
| F4 | 2.15 ± 0.06 |
| F5 | 2.31 ± 0.07 |
| F6 | 2.29 ± 0.16 |
| F7 | 2.17 ± 0.04 |
| F8 | 2.25 ± 0.09 |
| F9 | 2.11 ± 0.04 |
| F10 | 2.37 ± 0.17 |
| F11 | 2.11 ± 0.08 |
| pH | E.C. (µS) | Available P Content (mg/L) | Phosphate-Solubilizing Microbial Count (CFU/g) | Total Bacterial Count (CFU/g) | Total Fungal Count (CFU/g) |
|---|---|---|---|---|---|
| 7.14 ± 0.02 | 540.8 ± 0.31 | 43.303 ± 0.01 | 1 × 106 ± 0.33 | 1.5 × 1010 ± 0.16 | 1 × 107 ± 0.33 |
| Treatment | Soil Condition | Electrical Conductivity (µs) |
|---|---|---|
| T1-Control | Non-sterilized | 541.85 ± 0.03 e |
| T2-Biofertilizer | Non-sterilized | 318.85 ± 0.10 l |
| T3-Biofertilizer + TCP | Non-sterilized | 650.35 ± 0.27 a |
| T4-Biofertizer + ERP | Non-sterilized | 452.63 ± 0 31 j |
| T5-TCP | Non-sterilized | 538.13 ± 0.08 f |
| T6-ERP | Non-sterilized | 624.58 ± 0.03 c |
| T1-Control | Sterilized | 468.13 ±0.08 i |
| T2-Biofertilizer | Sterilized | 633.10 ± 0.07 b |
| T3-Biofertilizer + TCP | Sterilized | 522.83 ± 0.05 g |
| T4-Biofertizer + ERP | Sterilized | 575.60 ± 0.11 d |
| T5-TCP | Sterilized | 444.17 ± 0.13 k |
| T6-ERP | Sterilized | 475.80 ± 0.11 h |
| Treatment | Plant Height (cm) | Leaf Length (cm) | Leaf Width (cm) |
|---|---|---|---|
| Sterilized soil | |||
| T1 | 9.85 ± 0.15 a | 3.52 ± 0.08 a | 2.20 ± 0.11 a |
| T2 | 10.60 ± 0.53 a | 3.70 ± 0.09 a | 2.42 ± 0.08 a |
| T3 | 10.17 ± 0.47 a | 3.62 ± 0.04 a | 2.27 ± 0.15 a |
| T4 | 9.72 ± 0.32 a | 3.65 ± 0.06 a | 2.17 ± 0.15 a |
| T5 | 10.17 ± 0.52 a | 3.52 ± 0.05 a | 2.12 ± 0.07 a |
| T6 | 9.15 ± 0.48 a | 3.62 ± 0.05 a | 2.30 ± 0.11 a |
| Non-sterilized soil | |||
| T1 | 8.55 ± 0.39 b | 2.07 ± 0.39 d | 1.37 ± 0.06 b |
| T2 | 9.47 ± 0.56 b | 2.55 ± 0.06 bc | 1.60 ± 0.04 b |
| T3 | 9.12 ± 0.60 b | 2.52 ± 0.06 bc | 1.85 ± 0.35 b |
| T4 | 9.47 ± 0.40 b | 2.57 ± 0.02 b | 1.60 ± 0.00 b |
| T5 | 8.82 ± 0.38 b | 2.32 ± 0.075 bcd | 1.45 ± 0.09 b |
| T6 | 8.82 ± 0.38 b | 2.27 ± 0.02 cd | 1.70 ± 0.08 b |
| Treatment | Total Bacterial Count (Log CFU/g) | Total Fungal Count (Log CFU/g) | Total PSMs (Log CFU/g) |
|---|---|---|---|
| Sterilized soil | |||
| T1 | 8.60 ± 0.58 | 3.00 ± 1.20 | 3.90 ± 0.33 |
| T2 | 10.90 ± 1.45 | 5.47 ± 2.33 | 6.11 ± 0.58 |
| T3 | 10.95 ± 0.88 | 5.00 ± 3.05 | 6.00 ± 1.85 |
| T4 | 10.84 ± 3.48 | 5.00 ± 1.52 | 6.34 ± 2.18 |
| T5 | 10.60 ± 1.73 | 3.00 ± 1.15 | 10.95 ± 1.20 |
| T6 | 10.69 ± 2.51 | 3.30 ± 0.58 | 5.47 ± 0.58 |
| Non-sterilized soil | |||
| T1 | 10.90 ± 2.33 | 6.07 ± 1.45 | 3.30 ± 0.58 |
| T2 | 11.04 ± 1.45 | 3.77 ± 0.58 | 4.25 ± 0.33 |
| T3 | 11.07 ± 1.20 | 5.30 ± 1.52 | 5.90 ± 1.52 |
| T4 | 10.00 ± 1.52 | 3.30 ± 0.58 | 5.95 ± 2.02 |
| T5 | 10.00 ± 4.70 | 5.47 ± 0.88 | 5.90 ± 2.66 |
| T6 | 10.47 ± 2.64 | 3.69 ± 1.20 | 4.04 ± 0.58 |
Disclaimer/Publisher’s Note: The statements, opinions and data contained in all publications are solely those of the individual author(s) and contributor(s) and not of MDPI and/or the editor(s). MDPI and/or the editor(s) disclaim responsibility for any injury to people or property resulting from any ideas, methods, instructions or products referred to in the content. |
© 2023 by the authors. Licensee MDPI, Basel, Switzerland. This article is an open access article distributed under the terms and conditions of the Creative Commons Attribution (CC BY) license (https://creativecommons.org/licenses/by/4.0/).
Share and Cite
Mayadunna, N.; Karunarathna, S.C.; Asad, S.; Stephenson, S.L.; Elgorban, A.M.; Al-Rejaie, S.; Kumla, J.; Yapa, N.; Suwannarach, N. Isolation of Phosphate-Solubilizing Microorganisms and the Formulation of Biofertilizer for Sustainable Processing of Phosphate Rock. Life 2023, 13, 782. https://doi.org/10.3390/life13030782
Mayadunna N, Karunarathna SC, Asad S, Stephenson SL, Elgorban AM, Al-Rejaie S, Kumla J, Yapa N, Suwannarach N. Isolation of Phosphate-Solubilizing Microorganisms and the Formulation of Biofertilizer for Sustainable Processing of Phosphate Rock. Life. 2023; 13(3):782. https://doi.org/10.3390/life13030782
Chicago/Turabian StyleMayadunna, Nipuni, Samantha C. Karunarathna, Suhail Asad, Steven L. Stephenson, Abdallah M. Elgorban, Salim Al-Rejaie, Jaturong Kumla, Neelamanie Yapa, and Nakarin Suwannarach. 2023. "Isolation of Phosphate-Solubilizing Microorganisms and the Formulation of Biofertilizer for Sustainable Processing of Phosphate Rock" Life 13, no. 3: 782. https://doi.org/10.3390/life13030782
APA StyleMayadunna, N., Karunarathna, S. C., Asad, S., Stephenson, S. L., Elgorban, A. M., Al-Rejaie, S., Kumla, J., Yapa, N., & Suwannarach, N. (2023). Isolation of Phosphate-Solubilizing Microorganisms and the Formulation of Biofertilizer for Sustainable Processing of Phosphate Rock. Life, 13(3), 782. https://doi.org/10.3390/life13030782

